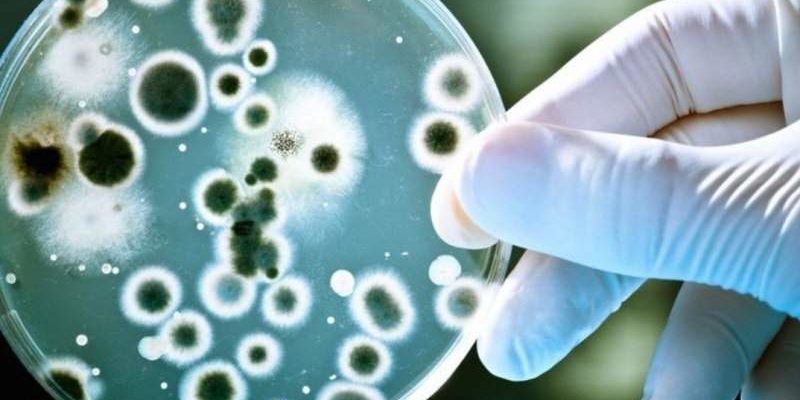
Открыты бактерии, влияющие на развитие рака легких

Открыты бактерии, влияющие на развитие рака легких

Открытые специалистами микробы манипулируют работой гамма-дельта Т-клеток.
Необычные бактерии, которые оказались способны влиять на иммунную систему так, чтобы ускоренно развивался рак легких, были открыты учеными из Массачусетского технологического института (США).
Это выяснилось во время экспериментов на генетически модифицированных мышах, склонных к заболеванию раком. У части грызунов легкие и кишечник были полностью очищены от бактерий, и впоследствии именно у них резко снизилась скорость роста опухолей, а также их частота. В среднем у таких мышей было в 2-3 раза меньше новообразований в легких по сравнению с мышами, у которых не удаляли бактерии. Размер и степень развития опухолей в легких у них также оказались значительно меньше.
Бактериями, влияющими на развитие рака легких, оказались микробы родов Herbaspirillum и Sphingomonadaceae. Из слов ученых следует, что раковые клетки стимулируют синтез этими микробами веществ, из-за которых интенсивнее выделяются интерлейкины Т-клеток. В таких условиях опухоль развивается особенно активно.
«Если мы создадим препарат, который будет избирательно блокировать рост этих микробов или мешать им манипулировать работой гамма-дельта Т-клеток, то тогда у нас появится новый способ борьбы с раком легких», — высказался в связи с этим ведущим специалист проекта Чэнчэн Цзин.
Отметим, что ученые не впервые открывают связь между развитием рака и влиянием проникающих в организм бактерий. В частности. бактерии Heliobacter pylori и Streptococcus gallolyticus считаются провокаторами развития рака желудка, а бактерию Bacteroides fragilis подозревают в способности способствовать появлению рака прямой кишки.
материал med2.ru